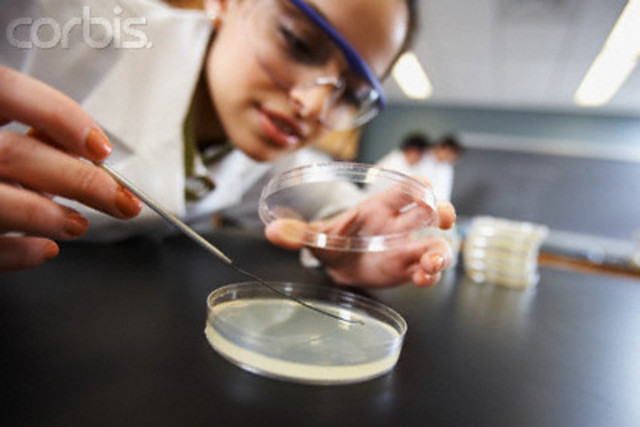
Hari rabu

-
Pada hari ini, saya belajar lima mata pelajaran. Saya lebih suka belajar bahasa Inggris!
-
Pada hari selasa saya belajar sejarah. Saya lebih tidak suka sejarah. Saya juga belajar olahraga. Pada hari selasa, saya bermain tenis.
-
Saya belajar Ilmu Pengetahuan Alam (IPA) pada Hari rabu, Hari kamis dan Hari jumat.
-
Di sekolah saya, ada tujuh belas ruang kelas. Sekolah saya besar dan modern! Ada tiga ratus enam puluh murid di SMU.
-
Pada hari ini, saya belajar mata pelajaran yang paling muda... Ilmu Pengetahuan Sosial (IPS). Saya suka belajar IPS. Pada beristirahat teman saya bermain bola basket. Sekolah selesai pada jam tiga lewat dua puluh.
Want to make a timeline like this?
Use Timetoast to turn dates, events, milestones, and phases into a clear visual timeline you can build and share. Timetoast is a timeline maker for work, school, research, and stories.